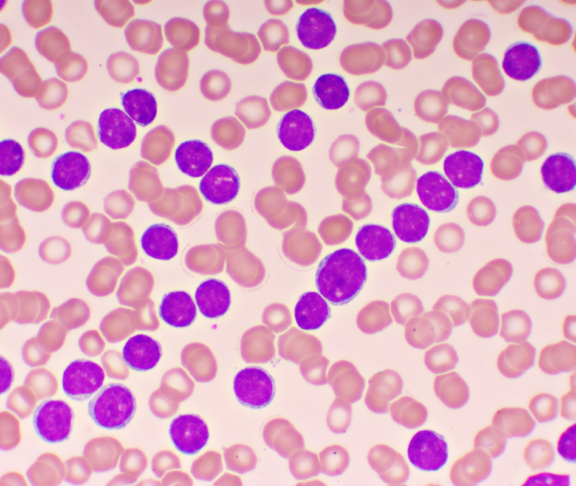
Blood picture of chronic lymphocytic leukemia or CLL, analyze by microscope, original magnification 1000x

Priv.-Doz.in Dr. in med. univ. Dr. in scient. med. Katharina Prochazka Fachärztin für Innere Medizin und Hämatologie in der Klinischen Abteilung für Hämatologie der Medizinischen Universität Graz , stellt die Chronische Lymphatische Leukämie (CLL) vor, von Symptomen und Verlauf über die Diagnose bis zu den Therapiemöglichkeiten.

Priv.-Doz.in Dr. in med. univ. Dr. in scient. med. Katharina Prochazka
© feelimage-matern
Fachärztin für Innere Medizin und Hämatologie in der Klinischen Abteilung für Hämatologie der Medizinischen Universität Graz
Was ist CLL? Warum ist das eine chronische Erkrankung?
Die CLL ist eine Krebserkrankung des lymphatischen Systems, zu dem Lymphknoten, Milz und Knochenmark zählen. Durch die Ausschwemmung der Zellen aus dem Knochenmark in das Blut (Leukämie), kann man die Erkrankung dort gut nachweisen. Ausgangspunkt dieser Blutkrebserkrankung (Leukämie) ist ein unkontrolliert wachsender (entarteter) B-Lymphozyt, eine Untergruppe der weißen Blutkörperchen, die eine wichtige Rolle im Immunsystem spielt.
‚Chronisch‘ steht bei einer CLL für das eher langsame Wachstum der B-Lymphozyten. Es kann sich über Monate und Jahre hinziehen. Die ersten Probleme auf Zellebene bleiben oft lange unbemerkt (stiller Verlauf). Die meisten Patient:innen sind über Jahre komplett stabil. Nur einige wenige haben einen raschen Verlauf und benötigen akute Behandlung.
Wen trifft die CLL typischerweise und warum bleibt die Erkrankung oft lange unbemerkt?
Die CLL ist die häufigste leukämische Erkrankung in Österreich. Prinzipiell sind die typischen CLL-Patient:innen bei der Erstdiagnose knapp über 70 Jahre alt. Wobei es auch Patient:innen aller Altersstufen gibt. Männer sind häufiger betroffen als Frauen. Spezielle Risikofaktoren sind nicht bekannt. Allerdings ist das Risiko, eine CLL zu entwickeln, leicht erhöht, wenn Blutsverwandte an einer Leukämie leiden. Die CLL ist nicht ererbt. Der stille Verlauf der CLL ist der Grund, warum sie oft lange unbemerkt bleibt. Das heißt, es gibt keine typischen Symptome. Die Diagnose der CLL ist daher häufig ein Zufallsbefund, der bei Blutuntersuchungen festgestellt wird, die im Zusammenhang mit medizinischen Maßnahmen wie einer OP stattfinden.
Warum entarten die B-Lymphozyten?
Das unkontrollierte Wachstum der B-Lymphozyten passiert im Rahmen ihrer Entwicklung aus einer Vorläuferzelle im Knochenmark. Durch die komplexe Reifung und Zellteilung der Immunzellen kommt es immer wieder zu Fehlern, die das Immunsystem irgendwann nicht mehr zu korrigieren vermag. So entzieht sich die Zelle der Kontrolle und kann ungehindert weiterwachsen.
Welche frühen Anzeichen oder Laborveränderungen sollten Hausärzt:innen oder Patient:innen hellhörig machen?
Eine erhöhte Zahl an weißen Blutzellen (Leukozyten) und/oder B-Lymphozyten sollte immer abgeklärt werden. Auch ein niedriger Hämoglobinwert (Blutarmut) kann auf eine CLL hinweisen, da die vermehrt wachsenden B-Lymphozyten gesunde Blutzellen im Knochenmark verdrängen. Frühe Anzeichen sind zudem geschwollene, jedoch nicht schmerzende Lymphknoten, Müdigkeit bis hin zu Erschöpfung (Fatigue) und ungewollter Gewichtsverlust. Manche Betroffene erleben vermehrten Nachtschweiß oder sind aufgrund der Blutarmut und der Verminderung der Blutplättchen sehr blass..
Welche Rolle spielt die molekulare Diagnostik bei der Erstabklärung und warum ist sie so entscheidend für die weitere Therapieplanung?
Die CLL verläuft sehr heterogen: Wir erleben milde Verläufe, wo über viele Jahre nichts passiert, und sehr aggressive Verläufe. Auf molekulargenetischer Ebene erheben wir unter anderem den IGHV-Status (Immunglobulin-Schwere-Kette-Variabel-Region-Gen), um eine Prognose zum Verlauf machen und eine Entscheidung zur Behandlung treffen zu können. Dieser Status ergibt entweder IGHV-mutiert oder IGHV-unmutiert. Ist Letzteres der Fall, verläuft die Erkrankung meist aggressiver. Außerdem untersuchen wir den Tumorsuppressor TP53, der Zellen vor unkontrolliertem Wachstum schützt. Ist das TP53-Gen defekt oder fehlt es, ist das für den Krankheitsverlauf meist ungünstig. Entsprechend der Befunde der molekularen Diagnostik unterteilen wir die Patient:innen in drei Risikogruppen: niedriges, mittleres und hohes Risiko für einen ungünstigeren Verlauf. Wobei es neben dem molekulargenetischen Risiko weitere Faktoren gibt, die die Wahl der Behandlung beeinflussen – darunter Alter, Fitness, Begleiterkrankungen und Medikamente, die eingenommen werden.
Wie haben sich die Therapien in den vergangenen Jahren verändert? Welche neuen, alltagstauglichen Ansätze ermöglichen Betroffenen heute eine bessere Lebensqualität?
Abgesehen von den Krankheitsfällen mit hohem Risiko für einen aggressiveren Verlauf ist das Ziel unserer Behandlungen eine zeitlich begrenzte Therapie – und damit eine möglichst lange Therapiefreiheit. Alle neuen Therapieansätze ordnen sich dem unter.1 Wer ein Jahr lang therapiert wird, ist dann beispielsweise drei, vier, fünf Jahre therapiefrei. Das heißt auch: Abnahme von Nebenwirkungen und Zunahme von Lebensqualität, unter Umständen auch weil die Krankheit in der therapiefreien Zeit gedanklich weniger stark präsent ist. Zudem hilft der Wechsel zwischen Therapie und therapiefrei, Resistenzen vorzubeugen. Grundsätzlich gibt es für die Therapie zwei Wege: Tabletten und Infusionen, auch in Kombination. Die orale Therapie ist natürlich alltagstauglicher, sie erlaubt eine höhere Planbarkeit. Wichtig zu wissen, ist, dass viele CLL-Patient:innen dank neuer Medikamente und Therapien mit einer normalen Lebenserwartung rechnen können.
Checkliste für das Arztgespräch
Bei einem Arztbesuch können viele Informationen gleichzeitig auf Sie einströmen. Es ist leicht, Details nicht sofort zu verstehen oder später zu vergessen. Diese Liste soll Ihnen helfen, den Überblick zu behalten. Notieren Sie sich am besten vorab weitere Fragen, die Ihnen wichtig sind.

Informationen für Ihre Ärztin/Ihren Arzt
- Welche Beschwerden haben Sie aktuell und seit wann treten sie auf?
- Welche Medikamente nehmen Sie regelmäßig ein? Bringen Sie am besten Ihren Medikamentenplan mit.
- Gibt es andere Erkrankungen oder chronische Leiden, die relevant sein könnten?
- Treten in Ihrer Familie Erkrankungen wie Krebs, Herzinfarkt oder Schlaganfall auf?
Mögliche Fragen direkt nach der Diagnose
- In welchem Stadium befindet sich meine Erkrankung?
- Welche Symptome könnten bei mir auftreten und wie sollte ich damit umgehen?
- Sind weitere Untersuchungen oder Tests erforderlich? Wenn ja, welche und wie oft?
- Wie dringend ist es, mit der Behandlung zu beginnen?
Fragen wenn noch keine Behandlung nötig ist
- Warum ist aktuell keine Therapie notwendig?
- Wie häufig sollten Kontrolluntersuchungen stattfinden?
- Wo finde ich weitere Informationen oder Unterstützung?
- Überlegen Sie vor Ihrem Termin, wie es Ihnen gerade geht – fühlen Sie sich eher belastet, nervös oder hoffnungsvoll?
Fragen vor Beginn einer Behandlung
- Welche Therapiemöglichkeiten gibt es?
- Was sind die Vor- und Nachteile der einzelnen Optionen?
- Liegen bei mir genetische Faktoren vor, die Verlauf oder Behandlung beeinflussen?
- Wie lange wird die Behandlung voraussichtlich dauern?
- Welche Nebenwirkungen sind möglich?
- Wie kann ich mich auf die Behandlung vorbereiten?
- Worauf sollte ich während der Therapie achten?
- Kann ich die Behandlung durch Sport, Ernährung oder Routinen unterstützen?
Quellen:
https://www.krebshilfe.net/fileadmin/user_upload/Dachverband/Downloads/Patientenleitfaden.pdfhttps://selpers.com/blutkrebs/gutes-leben-mit-cll-arztgespraech-und-kontrolltermine-bei-cll/
AT-16569, 03/2026